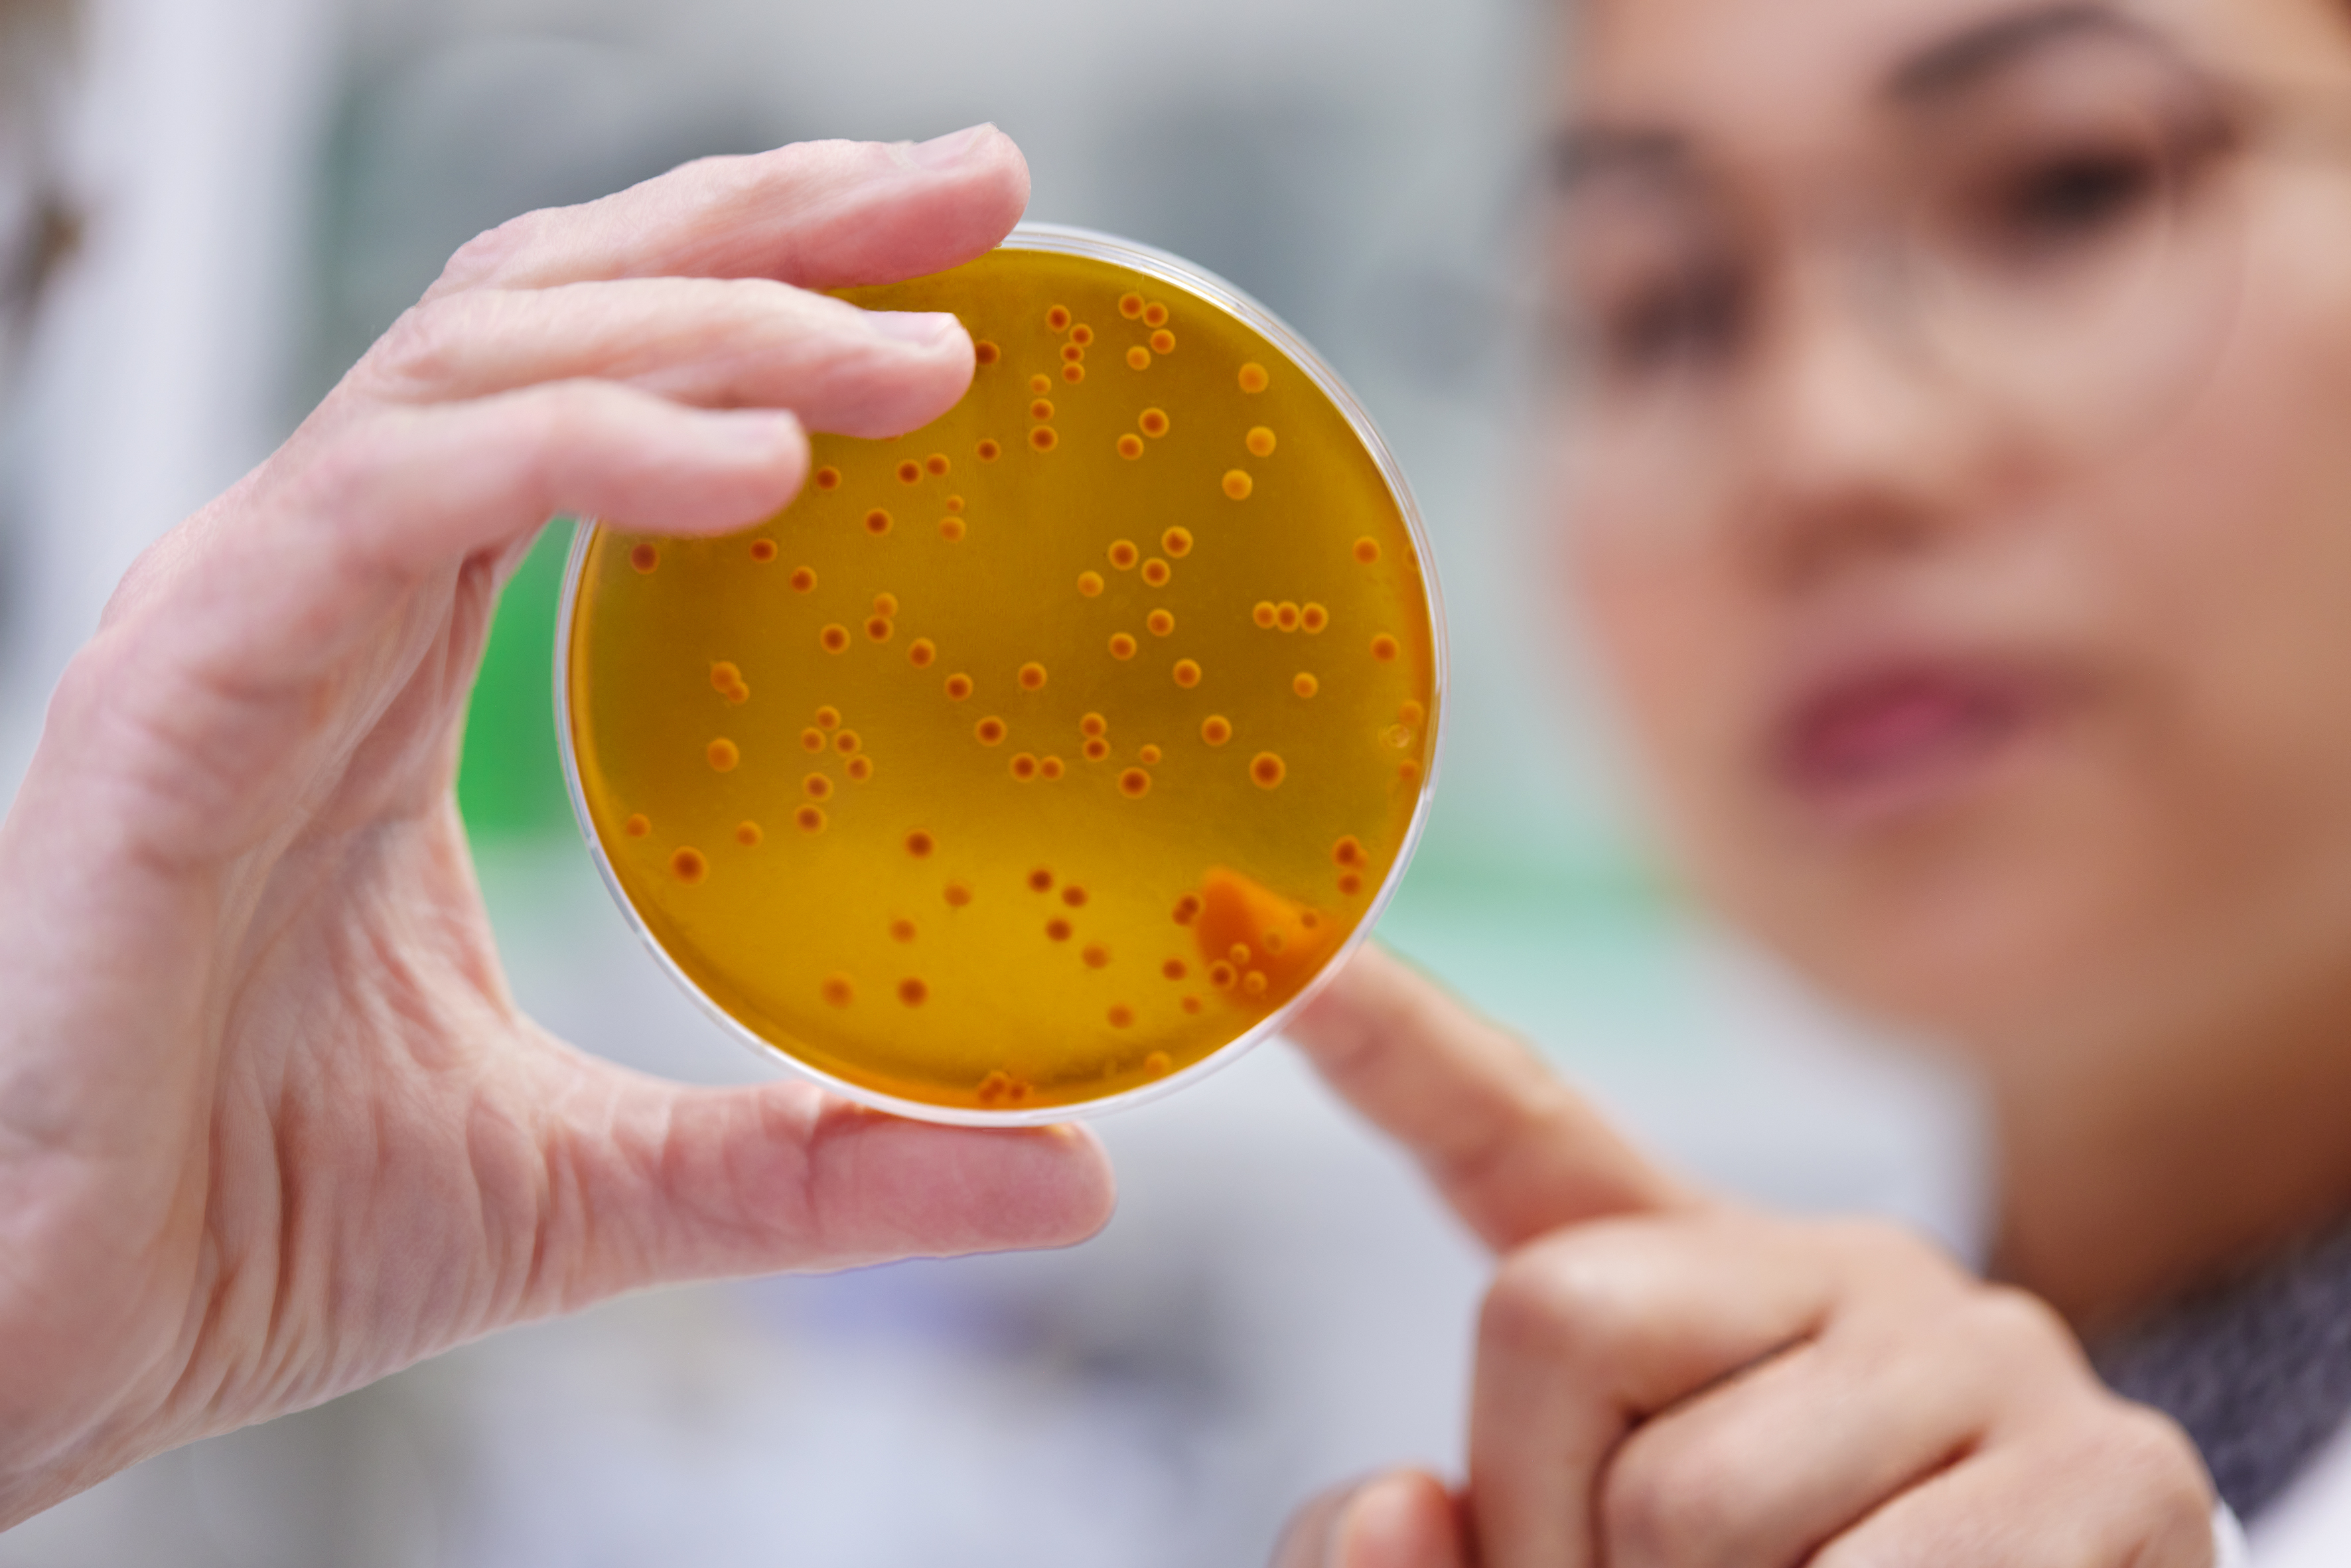

Probi, part of Symrise group, joins new Care & Wellness Division. Read more here.
We will be at Infarma, one of the largest pharmacy events within the region, in Madrid on March 24. Hope to be able to connect with you there!

Lactiplantibacillus plantarum 299v (LP299V®) has been documented within several areas, all related to health benefits in the gut. It is described in more than 290 scientific publications and has been subject to more than 80 clinical studies. Clinical results have been shown within areas reaching from inflammation to metabolic health. The extensive documentation and clinical evidence make this strain unique and ideal for building consumer loyalty.

Want to find out more about the mode of action for this unique probiotic strain? Tune in to our on-demand webinar to explore how gut health plays an essential role in many health indications and why this strain is ideal for building consumer loyalty.
Watch webinar
This highly robust probiotic strain is able to withstand the harsh conditions of the human gastrointestinal tract and adhere to intestinal epithelial cells, significantly boosting its health benefits. When freeze-dried, the LP299V strain remains active and stable at room temperature, facilitating a lengthy shelf-life for capsules, tablets, or powder sachets, and making it especially suitable for food applications and dietary supplements.
LP299V® is a trademark. The strain is patent-protected and approved for a wide range of indications and applications worldwide.
*Formerly known as Lactobacillus plantarum 299v

The LP299V® booklet summarizes the comprehensive science supporting the bacterial strain Lactiplantibacillus plantarum 299v. An opportunity to truly get to know and understand the benefits and the extensive research.
The booklet gives an overview of the in vitro, animal, and clinical studies with LP299V. It covers the knowledge on how this strain acts, the binding mechanism, the effects on the gut epithelium and mucosa production.
just a testing value, ignore this string please
Explore the mode of action of Lactiplantibacillus plantarum 299v, the most clinically documented L. plantarum strain in the world.

Probi combines innovative R&D, a keen knowledge of the latest trends, and state-of-the-art research to develop proven...

Probi® has spent more than thirty years investigating the safety and efficacy of our probiotic strains. We conduct...
Probi is an innovative, experienced provider of clinically proven biotic strains and solutions. We use our state-of-the-art...